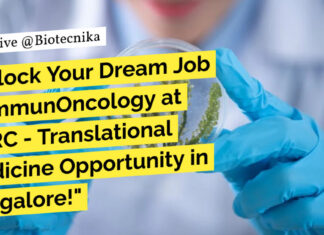
BBRC-Syngene Immuno-Oncology Scientist Recruitment – Apply Online BBRC-Syngene Immuno-Oncology Scientist Recruitment - Apply Online

Enveda Project Coordinator Role For MSc Candidates – Apply Online
Enveda Project Coordinator Role For MSc Candidates - Apply Online
Project Coordinator
Hyderabad, India
Operations – India Operations / Full-time / On-site
Proud to be recognized as one...
Paid Intern R&D Opportunity at HaystackAnalytics (IIT Bombay) – Apply Now!
Paid Biotech Internships, R&D at HaystackAnalytics (IIT Bombay) - Apply Now!
Intern Research & Development
Mumbai Metropolitan Region
About the Job
Position: Intern Research & Development
Location:...
IISc Teaching Assistants Recruitment – Non-NET Candidates Apply Online
IISc Teaching Assistant Jobs - Non-NET Candidates Apply Online
IISc Teaching Assistant Jobs - Non-NET Candidates Apply Online. Interested and eligible applicants can check out...
Biotecnika Times Newsletter 02.12.2024 – Freshers Wanted at Apotex, Non-NET JRF...
Freshers Wanted! BSc Apply For Clinical Research Associate at Apotex
Exciting opportunities for freshers in clinical research at Apotex. Apply now!
DBT-inStem JRF Recruitment – Non-NET...
Sharda University JRF Position Recruitment In DBT-Funded Project, Applications Invited
Sharda University JRF Position Recruitment In DBT-Funded Project, Applications Invited
Sharda University
Department of Biotechnology
Greater Noida 201310
Advertisement for the Post of Junior Research Fellow under DBT-Funded...
QTLomics Technologies Pvt Ltd Hiring For Field Application Scientist Role –...
QTLomics Technologies Hiring For Field Application Scientist Role - Apply Now
QTLomics Technologies Pvt Ltd
Field Application Scientist - Job Description
We are now looking for a...
BBRC-Syngene Immuno-Oncology Scientist Recruitment – Apply Online
BBRC-Syngene Immuno-Oncology Scientist Recruitment - Apply Online
BBRC-Syngene Immuno-Oncology Scientist Recruitment - Apply Online. Interested and eligible applicants can check out all of the details...
Vienna BioCenter Summer School 2025, 9-week Research Program for Life Science...
Vienna BioCenter Summer School 2025 - 9-week Research Program for Life Science Undergrads at one of Europe's leading Research Centers
Summer 2025 Call Now Open
Deadline...
IQVIA Document Coordinator Job For BSc Candidates – Apply Online
IQVIA BSc Microbiology Jobs - Biology & Biotech Apply Online
Senior Regulatory Document Coordinator
Location: Thāne, India
Employment Type: Full-time
Job ID: R1454072
Job Description
Job Overview
Supports the preparation of...
Cytiva MSc Scientist Job Opening – Apply Online
Cytiva MSc Biochemistry Job Opening - Apply Online For Scientist Role
Cytiva, Bangalore, Karnataka, India
Category: Science
Job Id: R1274266
Location: Bangalore, Karnataka, India
The Scientist I for Cytiva...
Freshers Wanted! BSc Apply For Clinical Research Associate at Apotex
Freshers Clinical Research Jobs at Apotex - BSc Life Sciences Apply Online
Clinical Research Associate
Date: Nov 30, 2024
Location: Bangalore, KA, IN, 560099
Company: Apotex
About Apotex Inc.
Apotex...
CSIR-IGIB Bioinformatics, Data Science Project Associate Recruitment – Applications Invited Online
IGIB MSc Bioinformatics Project Vacancy - Apply Online
About CSIR-IGIB
CSIR-Institute of Genomics & Integrative Biology (IGIB) is a premier research institute under the Council of...
DBT-inStem JRF Recruitment – Non-NET Candidates Can Apply Online
inStem Life Science JRF Recruitment - Non-NET Candidates Can Apply Online
Institute for Stem Cell Science and Regenerative Medicine (DBT-inStem)
(An AI under Department of Biotechnology,...
IMTECH Project Job – Applications Invited Online
IMTECH Biological Sciences Project Job - Applications Invited Online
ROLLING ADVT. NO. 2024-11-02
Project Title: “Identification of novel inhibitors of aminoglycoside acetyltransferase, MtbEis, causing drug resistance...
Principal Project Associate at ICGEB – Apply Now!
ICGEB PhD Project Associate Job Opening - Life Sciences Apply
VACANCY NOTICE
Principal Project Associate – 1 Position
A Principal Project Associate position is available in the...